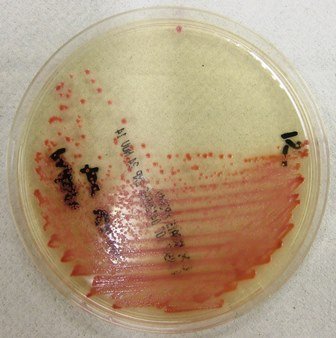

MRSA screen (screen nose groin)
Microbiology
Notes
- The information given here is intended for use by healthcare professionals. Please see Lab Tests Online-UK for more general advice, links and background.
- For current guidance please see Infection Control Policy on MRSA and Guide to MRSA Screening poster
- New positive hospital cases will be notified by the Infection Control team
- Dry swabs (no transport medium) and standard charcoal transport swabs are both suitable for MRSA screening, but dry swabs are cheaper
- The following sites are screened:
- nose and groin
- any wounds (including umbilicus in neonates) and entry sites
- urine (if catheterised)
- sputum (if productive)
- other swabs as directed by Infection Control Nurses
- swabs from other sites (e.g. axilla, throat) will not be processed, unless these are required by another healthcare provider and this is made clear on the request form
Sample requirements

Dry swab - these should only be used for MRSA screens. Moisten swabs with sterile saline or water before use.
Do not tip saline/water into the swab tube.

Standard charcoal transport swab
Place swab into transport medium

30 mL sterile Universal for urine.
Urine samples sent in red capped 30 mL sterile universal containers are also accepted.

60 mL wide-mouthed container for sputum
Required information
- Reason for screening e.g. admission, transfer, post-decolonisation check, contact
- If testing is required for another heathcare provider
Storage/transport
Store and transport at room temperature
Turnaround time
Negative: 1 - 2 days
Positive: 2 - 4 days
Getting the swabs you need (for Gloucestershire Hospitals staff)
Pathology Stores at both sites hold supplies of the appropriate specimen containers, bags, forms and equipment needed for sample testing. Trust departments and wards can contact Pathology stores for the MRSA swabs and specimen containers they need, you can do this by:
1. Sending a paper order request form
2. Phoning Pathology stores
- Cheltenham General Hospital Pathology Stores Tel: 0300 422 4077
- Gloucestershire Royal Hospital Pathology Stores Tel: 0300 422 5275
Opening hours are 8am to 4pm (Monday to Friday).
3. Emailing Pathology stores
- Cheltenham - ghn-tr.pathology.storescgh@nhs.net
- Gloucester - ghn-tr.pathology.storesgrh@nhs.net
There is no restriction on stock allocation, and the team generally provide what is requested.
The team in Pathology stores will put the ordered stock on the porter’s shelf for collection. Department/ ward teams advise ‘my porter’ that collection is required.
You can also come and collect the stock directly form stores/or Pathology reception, the team facilitate this whenever possible.